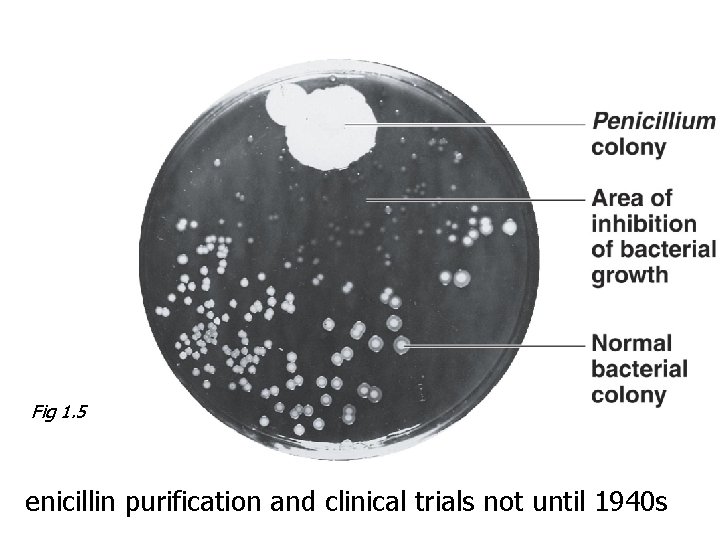
Fig 1. 5 enicillin purification and clinical trials not until 1940 s

You do not really understand something unless you






































- Slides: 38


“You do not really understand something unless you can explain it to your grandmother. ” --Albert Einstein

Course Introduction Textbook, some special features: Learning objectives Foundation Figures Clinical Focus Boxes End of chapter study outline Check your understanding questions and EOC study questions Cutting Edge Media Supplements on Tortora Textbook Website Lab exercises: In-house Manual Research Projects and Presentations

First Homework (worth 4 pts. ) Due Saturday 11 PM of the first week of school. Log on to Blackboard http: //clpccd. blackboard. com and enter the Microbiology 1 class site (1 pt. ) Go to “Tools”, then “Personal Information”. Make sure the correct email address has been entered. (1 pt. ) Now go to “Change Password” and choose your own password. Review all pages of the syllabus carefully! (2 pts. )

First Homework cont. : Student Info Sheet Fill out the student info sheet that you received during the first class period. Turn it back in by the first lab session of the 2 nd week. Worth 1 more point.

Chapter 1 The Microbial World and You Objectives List some ways in which microbes affect your live Use scientific nomenclature : Genus and a specific epithet. List the three domains. Explain the importance of observations made by van Leeuwenhoek. Compare spontaneous generation and biogenesis. Describe experiments that helped to prove biogenesis. Highlight the major achievements of Pasteur and Koch. Identify the important work of Semmelweis and Lister. Identify the contributions to microbiology made by Jenner, Ehrlich and Fleming. Define bacteriology, mycology, parasitology, immunology, and virology. Explain the importance of recombinant DNA technology. List two examples of biotechnology that use recombinant DNA. Define normal microbiota and resistance. Define and describe several infectious diseases.

Microbes help us by decomposing organic waste performing photosynthesis producing ethanol, acetone, vinegar, cheese, bread, . . . producing insulin and many other drugs . . . Microbes harm us by • •

Naming and Classifying Microorganisms Carolus Linnaeus established the system of scientific nomenclature in 1739. Each organism has two names Binomial nomenclature: Genus + specific epithet (species) Italicized (or underlined), genus capitalized, “latinized”, used worldwide. May be descriptive or honor a scientist.

Examples Staphylococcus aureus (S. aureus) Escherichia coli (E. coli) Streptococcus pneumoniae (S. pneumoniae) 1857 – 1911

Types of Microorganisms Bacteria Archaea Fungi Protozoa Algae Viruses Multicellular animal parasites Prions

Bacterium / Bacteria Prokaryotic Peptidoglycan cell wall Reproduction by binary fission Gain energy from use of • organic chemicals • inorganic chemicals or • photosynthesis

Archaea Prokaryotic No peptidoglycan Live in extreme environments Include Methanogens Extreme halophiles Extreme thermophiles Figure 4. 5 b

Fungus/Fungi Eukaryotic Chitin cell walls Use organic chemicals for energy. Molds and mushrooms are multicellular consisting of masses of mycelia, which are composed of filaments called hyphae. Yeasts are unicellular.

Protozoan / Protozoa Eukaryotes Absorb or ingest organic chemicals May be motile via pseudopods, cilia, or flagella

Viruses Are acellular Have either DNA or RNA in core Core is surrounded by a protein coat. Coat may be enclosed in a lipid envelope. Viruses only replicate within a living host cell.

Multicellular Animal Parasites Eukaryotes Multicellular animals Helminths are parasitic flatworms and round worms Microscopic stages in life cycles

Three Domain Classification Bacteria Archaea Eukarya Protista Fungi Plants Animals

Microbiology History The Beginnings Ancestors of bacteria were the first life on Earth 1665: Cell theory – Robert Hooke 1673: First microbes observed – Anton van Leeuwenhoek n Compare to Fig 1. 2

The Transition Period: Debate over Spontaneous Generation Aristotles’s doctrine of spontaneous generation. Hypothesis that living organisms arise from nonliving matter; a “vital force” forms life Biogenesis: Hypothesis that the living organisms arise from preexisting life

1668: Francesco Redi the beginnings of experimental science filled 6 jars with decaying meat Conditions Results Three jars covered with fine net No maggots Three open jars Maggots appeared From where did the maggots come? What was the purpose of the sealed jars? Spontaneous generation or biogenesis?

1745: John Needham Objections Put boiled nutrient broth into covered flasks Conditions Results Nutrient broth heated, then placed in sealed flask Microbial growth From where did the microbes come? Spontaneous generation or biogenesis?

1765: Lazzaro Spallanzani boiled nutrient solutions in flasks Conditions Results Nutrient broth placed in flask, heated, then sealed No microbial growth Spontaneous generation or biogenesis?

1861: Louis Pasteur demonstrated that microorganisms are present in the air Conditions Results Nutrient broth placed in flask, heated, not sealed Microbial growth Nutrient broth placed in flask, heated, then sealed No microbial growth Spontaneous generation or biogenesis?

Confirmation of Biogenesis Pasteur’s S-shaped (swan-neck ) flask kept microbes out but let air in Figure 1. 3

The Golden Age of Microbiology(1857 -1914) Microbiology established as a science Louis Pasteur Spontaneous generation disproved Wine fermentation (yeasts and bacteria) Pasteurization

Pre-Pasteur: Ignaz Semmelweis (1840 s) – hand disinfection and puerperal fever Based on Pateur’s and Semmelweis’ findings: Joseph Lister (1860 s) – antiseptic surgery (phenol)


Robert Koch Work on anthrax proves the germ theory of disease Procedures become Koch's postulates (see Ch 14) Development of pure culture technique Nobel Prize in 1905 Nobelprize. org

Before the Golden Age Period: The Birth of Vaccination Jenner and smallpox vaccination (1796) ~ 100 years later: Pasteur shows how vaccinations work. (Creation of avirulent strains of bacteria during extended laboratory cultivation)

The Birth of Modern Chemotherapy 1910: Paul Ehrlich developed a synthetic arsenic drug, salvarsan, to treat syphilis 1930 s: Synthesis of sulfonamides 1928: Alexander Fleming and the discovery of the first antibiotic Fig 1. 5
Fig 1. 5 enicillin purification and clinical trials not until 1940 s

Modern Developments in Microbiology Bacteriology – Mycology – Parasitology – Virology – Immunology Microbial genetics and molecular biology lead to Recombinant DNA Technology (genetic engineering). Prokaryotic model system: E. coli

Selected Nobel Prizes for Microbiology Research 1901 von Behring Diphtheria antitoxin 1902 Ross Malaria transmission 1905 Koch TB bacterium 1908 Metchnikoff Phagocytes 1945 Fleming, Chain, Florey Penicillin 1952 Waksman Streptomycin 1969 Delbrück, Hershey, Luria Viral replication 1987 Tonegawa Antibody genetics 1997 Prusiner Prions 2005 Marshall & Warren H. pylori & ulcers

Microbes and Human Disease – Again many Challenges – Normal microbiota (flora) in and on the human body Pathogens overcome the host’s resistance infectious disease Antimicrobial resistance Bioterrorism (Re-)emerging infectious diseases (EID): WNE, avian influenza, SARS, BSE, HIV/AIDS. . .

West Nile Encephalitis Caused by West Nile virus First diagnosed in the West Nile region of Uganda in 1937 Appeared in New York City in 1999 Avian influenza A Influenza A virus (H 5 N 1) Primarily in waterfowl and poultry Sustained human-to-human transmission has not occurred yet

MRSA Methicillin-resistant Staphylococcus aureus 1950 s: Penicillin resistance developed 1980 s: Methicillin resistance 1990 s: MRSA resistance to vancomycin reported VISA: Vancomycin-intermediate-resistant S. aureus VRSA: Vancomycin-resistant S. aureus Bovine Spongiform Encephalopathy Caused by a prion Also causes Creutzfeldt-Jakob disease (CJD). New variant CJD in humans is related to beef consumption

Escherichia coli O 157: H 7 Toxin-producing strain of E. coli First seen in 1982 Leading cause of diarrhea worldwide Figure 25. 12

Acquired immunodeficiency syndrome (AIDS) Caused by human immunodeficiency virus (HIV) First identified in 1981 Worldwide epidemic infecting 30 million people; 14, 000 new infections every day Sexually transmitted infection affecting males and females HIV/AIDS in the U. S. : 30% are female, and 75% are African American The End